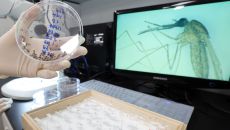

이슈뉴스
-

혈액 수급 어려워지자 "생명 살리기 위해서 우리 피라도"
"폭염과 한파 등 계절적 영향에 따라 헌혈자가 줄어 혈액 수급에 어려움이 반복되는 상황이어서 위기 극복에 조금이라도 보탬이 되- 2025.08.19 15:59
- 아시아경제
-

대구서 올해 첫 SFTS 사망자 발생···지난해보다 확진 사례↑
대구지역에서 올해 처음으로 중증열성혈소판감소증후군(SFTS) 사망자가 발생했다. 19일 대구시에 따르면, 지난달 초 60대 여- 2025.08.19 15:59
- 경향신문
-

대구 거주 60대, 올해 첫 SFTS 사망… 심층 역학조사 중
대구시는 지역에서 올해 첫 중증열성혈소판감소증후군(SFTS) 사망자가 발생했다고 19일 밝혔다. 사망자는 대구에 거주하는 60- 2025.08.19 15:51
- 세계일보
-

전북도교육청, 교사에 음란사진·문자 전송은 “교권침해” 재인정
전북도교육청이 도내 한 고교에서 발생한 여교사 성희롱 사건을 ‘교권 침해’로 재인정했다. 지역 교원단체들은 “상식이 회복됐다”- 2025.08.19 15:46
- 세계일보
-

함양군, 찾아가는 의료서비스 '농촌 왕진버스' 첫 운영
(함양=연합뉴스) 박정헌 기자 = 경남 함양군은 19일 지곡면 다목적회관에서 지역민 300여명을 대상으로 '농촌 왕진버스 사업- 2025.08.19 15:44
- 연합뉴스
-
“몸 덜덜·호흡곤란 증상 있다면 의심을”… 말라리아 경보, 전국 확대 발령
말라리아 경보가 19일 전국으로 발령됐다. 질병관리청은 최근 채집한 말라리아 매개모기인 얼룩날개모기류에서 올해 처음으로 삼일열- 2025.08.19 15:40
- 세계일보
-

대구 올해 첫 SFTS 사망자 발생…심층 역학조사 중
(대구=연합뉴스) 한무선 기자 = 대구시는 지역에서 올해 첫 중증열성혈소판감소증후군(SFTS) 사망자가 발생했다고 19일 밝혔- 2025.08.19 15:28
- 연합뉴스
-

시력회복? 백내장 예방?..허위·과장 '눈 영양제' 광고 기승
[이데일리 안치영 기자] 최근 눈 건강에 대한 관심이 증가하면서 루테인, 지아잔틴, 아스타잔틴 등 이른바 ‘눈 영양제’가 활발- 2025.08.19 15:17
- 이데일리
-

나주시, 휴가철 모기 매개 감염병 예방수칙 준수 당부
전남 나주시는 19일 여름 휴가철 해외여행 및 야외활동 증가에 따라 모기 매개 감염병 예방을 위해 시민들의 각별한 주의를 당부- 2025.08.19 15:04
- 아시아경제
-

학교 급식 조리원 만성 구인난 겪는 서초구, “이제 식판 씻지마세요”
지난해 5월 서울 서초구의 한 중학교에 부실급식 논란이 불거졌다. 온라인 커뮤니티에 올라온 급식사진이 문제가 된 것이다. 당시- 2025.08.19 15:04
- 경향신문
-

참좋은사람들사랑나눔공동체, 정읍시에 커피·샴푸·손세정제 기부
"취약계층 지원 위한 지역사회 나눔 활동을 지속 추진" [더팩트 | 정읍=곽시형 기자] 유영준 사단법인 참좋은사람들사랑나눔공동- 2025.08.19 14:38
- 더팩트
-

'원조 라면축제' 명성 잇는다…2025 구미라면축제 준비 박차
우리나라 라면의 메카로 굳건히 자리매김한 경북 구미시가 더욱 더 성숙하고 완성도 높은 '2025 구미라면축제'의 성공을 위해- 2025.08.19 14:22
- 아주경제
-

박형대 전남도의원, '한미 관세협상 분석·농업 대응 방안 토론회' 개최
오미화 의원과 공동 주최…이해영 교수 초청해 협상 결과 진단 [더팩트ㅣ무안=김동언 기자] 전남도의회는 박형대 의원이 18일 오- 2025.08.19 14:14
- 더팩트
-

대전재난심리회복지원센터, 쪽방촌·농촌·현장 노동자 대상 재난심리회복지원 활동
[더팩트ㅣ대전=선치영 기자] 대한적십자사 대전세종지사 대전재난심리회복지원센터는 19일 대전역 인근 쪽방촌 일대 및 지하상가에서- 2025.08.19 14:10
- 더팩트
-

인천공항 올해 최고 맛집은?
“인천공항 대표 맛집은 어디일까?” 인천국제공항공사는 인천공항 내 우수한 식음 서비스 발굴 및 식음 서비스 품질향상을 위해 ‘- 2025.08.19 14:08
- 세계일보
-

광주시교육청, 2026 수능 원서 21일부터 접수
광주시교육청은 오는 21일부터 9월5일까지 2026학년도 대학수학능력시험 응시원서를 접수한다고 19일 밝혔다. 원서 접수는 6- 2025.08.19 13:54
- 아시아경제
-

광주시교육청, 2026년 대학수능시험 원서접수
광주시교육청은 오는 21일부터 9월 5일 오후 5시까지(주말 제외) 2026학년도 대학수학능력시험 원서 접수를 진행한다고 19- 2025.08.19 13:03
- 서울신문
-

낙동강 녹조경보 개선…'수돗물 취수구' 근처 조사해 당일 발령
(서울=연합뉴스) 이재영 기자 = 낙동강 녹조 경보 체계가 개선된다. 아울러 가축분뇨의 하천 유입 차단 등을 포함한 녹조 종합- 2025.08.19 12:00
- 연합뉴스
-

금천구, 저장강박가구 주거환경 개선 나선다[동네방네]
[이데일리 함지현 기자] 금천구는 사회복지법인 네트워크, 장애인기업 이음과 ‘저장강박가구 주거환경개선사업’ 업무협약을 체결했다- 2025.08.19 11:45
- 이데일리
-

계룡시문화관광재단, '계룡軍문화축제' 위해 우수 축제 벤치마킹·홍보활동
[더팩트ㅣ계룡=정예준 기자] 충남 계룡시문화관광재단은 지난 15일 '2025계룡軍문화축제' 개막 30여 일을 앞두고 '우수 축- 2025.08.19 11:14
- 더팩트
-

전국에 '말라리아 경보' 발령…올해 첫 원충 감염 모기 확인
국내에서 올해 처음으로 삼일열말라리아 원충에 감염된 모기가 확인되면서 전국에 말라리아 경보가 발령됐다. 질병관리청은 말라리아- 2025.08.19 11:05
- 아시아경제
-

국내 모기서 말라리아 원충 올해 첫 확인…"모기 조심해야"
[이데일리 안치영 기자] 국내에 서식 중인 모기에서 올해 처음으로 말라리아 원충이 확인됐다. 모기에 물리지 않고록 주의해야 하- 2025.08.19 11:03
- 이데일리
-

강원교육청, 코로나 재유행에 감염병 확산 방지 총력
(춘천=연합뉴스) 박영서 기자 = 강원특별자치도교육청은 2학기 개학기를 맞아 학생 안전을 최우선으로 하는 감염병 확산 방지 계- 2025.08.19 10:56
- 연합뉴스
-

질병청, 전국에 말라리아 경보 발령…"양성 모기 확인"
(서울=연합뉴스) 성서호 기자 = 질병관리청은 최근 채집한 말라리아 매개 모기(얼룩날개모기류)에서 올해 처음으로 삼일열 말라리- 2025.08.19 10:53
- 연합뉴스
-

봉화군 보건소, 하절기 방역기동반 운영…유충 구제부터 행사장 방역까지
봉화군 보건소가 모기와 진드기 등 해충으로 인한 감염병 확산을 막기 위해 오는 10월까지 방역소독사업을 대대적으로 실시한다"- 2025.08.19 10:41
- 메트로신문사

